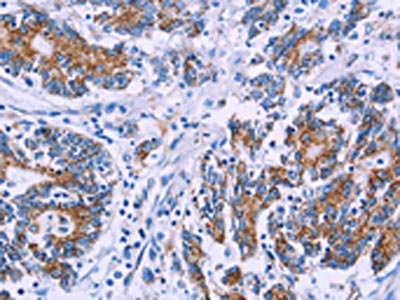

AGFG1 Antibody
-
中文名稱:AGFG1兔多克隆抗體
-
貨號:CSB-PA030856
-
規格:¥1100
-
圖片:
-
The image on the left is immunohistochemistry of paraffin-embedded Human breast cancer tissue using CSB-PA030856(AGFG1 Antibody) at dilution 1/50, on the right is treated with fusion protein. (Original magnification: ×200)
-
The image on the left is immunohistochemistry of paraffin-embedded Human colon cancer tissue using CSB-PA030856(AGFG1 Antibody) at dilution 1/50, on the right is treated with fusion protein. (Original magnification: ×200)
-
Gel: 8%SDS-PAGE, Lysate: 40 μg, Lane 1-5: A172 cells, Hela cells, 293T cells, K562 cells, human testis tissue, Primary antibody: CSB-PA030856(AGFG1 Antibody) at dilution 1/533, Secondary antibody: Goat anti rabbit IgG at 1/8000 dilution, Exposure time: 40 seconds
-
-
其他:
產品詳情
-
Uniprot No.:
-
基因名:AGFG1
-
別名:AGFG1 antibody; AGFG1_HUMAN antibody; Arf-GAP domain and FG repeats-containing protein 1 antibody; ArfGAP with FG repeats 1 antibody; AU045498 antibody; C130049H11Rik antibody; C85612 antibody; D730048C23Rik antibody; DKFZp686I15205 antibody; HIV 1 Rev binding protein antibody; HIV-1 Rev-binding protein antibody; HRB antibody; MGC116375 antibody; MGC116938 antibody; MGC116940 antibody; Nucleoporin like protein RIP antibody; Nucleoporin-like protein RIP antibody; RAB antibody; Rev interacting protein antibody; Rev-interacting protein antibody; Rev/Rex activation domain-binding protein antibody; RIP antibody
-
宿主:Rabbit
-
反應種屬:Human,Mouse,Rat
-
免疫原:Fusion protein of Human AGFG1
-
免疫原種屬:Homo sapiens (Human)
-
標記方式:Non-conjugated
-
抗體亞型:IgG
-
純化方式:Antigen affinity purification
-
濃度:It differs from different batches. Please contact us to confirm it.
-
保存緩沖液:-20°C, pH7.4 PBS, 0.05% NaN3, 40% Glycerol
-
產品提供形式:Liquid
-
應用范圍:ELISA,WB,IHC
-
推薦稀釋比:
Application Recommended Dilution ELISA 1:2000-1:5000 WB 1:500-1:2000 IHC 1:50-1:200 -
Protocols:
-
儲存條件:Upon receipt, store at -20°C or -80°C. Avoid repeated freeze.
-
貨期:Basically, we can dispatch the products out in 1-3 working days after receiving your orders. Delivery time maybe differs from different purchasing way or location, please kindly consult your local distributors for specific delivery time.
-
用途:For Research Use Only. Not for use in diagnostic or therapeutic procedures.
相關產品
靶點詳情
-
功能:Required for vesicle docking or fusion during acrosome biogenesis. May play a role in RNA trafficking or localization. In case of infection by HIV-1, acts as a cofactor for viral Rev and promotes movement of Rev-responsive element-containing RNAs from the nuclear periphery to the cytoplasm. This step is essential for HIV-1 replication.
-
基因功能參考文獻:
- Necroptotic RIP1 phosphorylation and ubiquitination seem to be tightly coordinated: inhibition or absence of RIP1 kinase activity blocks necroptotic RIP1 ubiquitination, whereas mutation of RIP1 necroptosis-associated ubiquitination site (K115R) dampens RIP1 kinase activity during necroptotic signaling. PMID: 27518435
- HRB knock-down affected CD4 downregulation induced by Nef but not by HIV-1 Vpu. PMID: 26701340
- Selenite caused CYLD upregulation via LEF1 and cIAP downregulation, both of which contribute to the degradation of ubiquitin chains on RIP1 and subsequent caspase-8 activation and colorectal tumor cell apoptosis. PMID: 24577083
- The top primary GWAS association of Airway hyperresponsiveness was in rs6731443 (P-value 2.5E-06) located within the AGFG1 genes. PMID: 23984888
- Association ofalpha-synuclein with Rab attachment receptor protein and soluble sensitive factor attachment receptors (SNAREs) highlights a key role for membrane transport defects in alpha-synuclein-mediated pathology. PMID: 21439320
- The authors show that cells lacking functional HRB have significantly reduced production of influenza virus progeny and that this defect results from impaired viral ribonucleoprotein (vRNP) delivery to the plasma membrane. PMID: 21752912
- hRIP is an essential cellular Rev cofactor, which acts at a previously unanticipated step in HIV-1 RNA export. PMID: 14701878
- Study demonstrates that the clathrin-mediated endocytosis of the SNARE VAMP7 is directly mediated by Hrb, a clathrin adaptor and ArfGAP. PMID: 18775314
- HRB is involved in clathrin-dependent endocytosis and recruits TI-VAMP in this process PMID: 18819912
顯示更多
收起更多
-
亞細胞定位:Nucleus. Cytoplasmic vesicle.
-
組織特異性:Ubiquitously expressed.
-
數據庫鏈接:
Most popular with customers
-
-
YWHAB Recombinant Monoclonal Antibody
Applications: ELISA, WB, IHC, IF, FC
Species Reactivity: Human, Mouse, Rat
-
Phospho-YAP1 (S127) Recombinant Monoclonal Antibody
Applications: ELISA, WB, IHC
Species Reactivity: Human
-
-
-
-
-